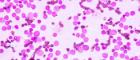
Acute Myeloid Leukaemia cells under a microscope

News
Bioengineered bone marrow model successfully used in leukaemia research
Wed, 05 Nov 2025 00:01:00 GMT
UofG’s Centre for Virus Research (CVR) launches new Translational Hub
Mon, 18 Aug 2025 10:00:33 BST
New discovery could halt secondary breast cancer growth
Mon, 28 Jul 2025 10:00:00 BST
New research discovery could advance drug treatments for diabetes and obesity
Wed, 18 Jun 2025 16:00:00 BST
Scotland has a high incidence of chronic disease. There are rising numbers of people living with multiple long-term disorders, impacting on quality of life and increasing costs to the NHS.
The University’s Clinical Innovation Zone at the Queen Elizabeth University Hospital (QEUH) campus is now Scotland’s focal point for the implementation of precision medicine. The Zone is home to the Precision Medicine Scotland Innovation Centre (PMS-IC, formerly the Stratified Medicine Scotland Innovation Centre).
Precision Medicine is an approach which enables doctors and researchers to identify and develop treatments that are effective for particular groups of patients, using advanced genomic, imaging and information technologies. Precision medicine will ensure that the right patient gets the right treatment at the right time, and will provide safer and more cost-effective treatments.
Partnering with NHS Greater Glasgow & Clyde, the University of Glasgow has driven Scotland’s vision in precision medicine, including the development of over £80m infrastructure to support precision medicine clinical trials at the QEUH. Our £32m Imaging Centre of Excellence (ICE) includes Scotland’s only 7 Tesla MRI scanner, an ultra-high resolution scanner, which is the first of its kind fully integrated within a clinical site in the UK. ICE will drive the development of imaging technology to understand and benefit diseases such as stroke, brain tumours and multiple sclerosis.
The University is one of Innovate UK’s Precision Medicine Centres of Excellence and our ambition is to be a global centre of excellence for chronic disease, precision medicine and imaging. Capitalising on our investment in infrastructure and biomedical researchers to drive international research excellence and patient benefits, and deliver economic benefit for Scotland and the UK.
Supporting the United Nations Sustainable Development Goals:

Find out more: Sustainable Development Goals